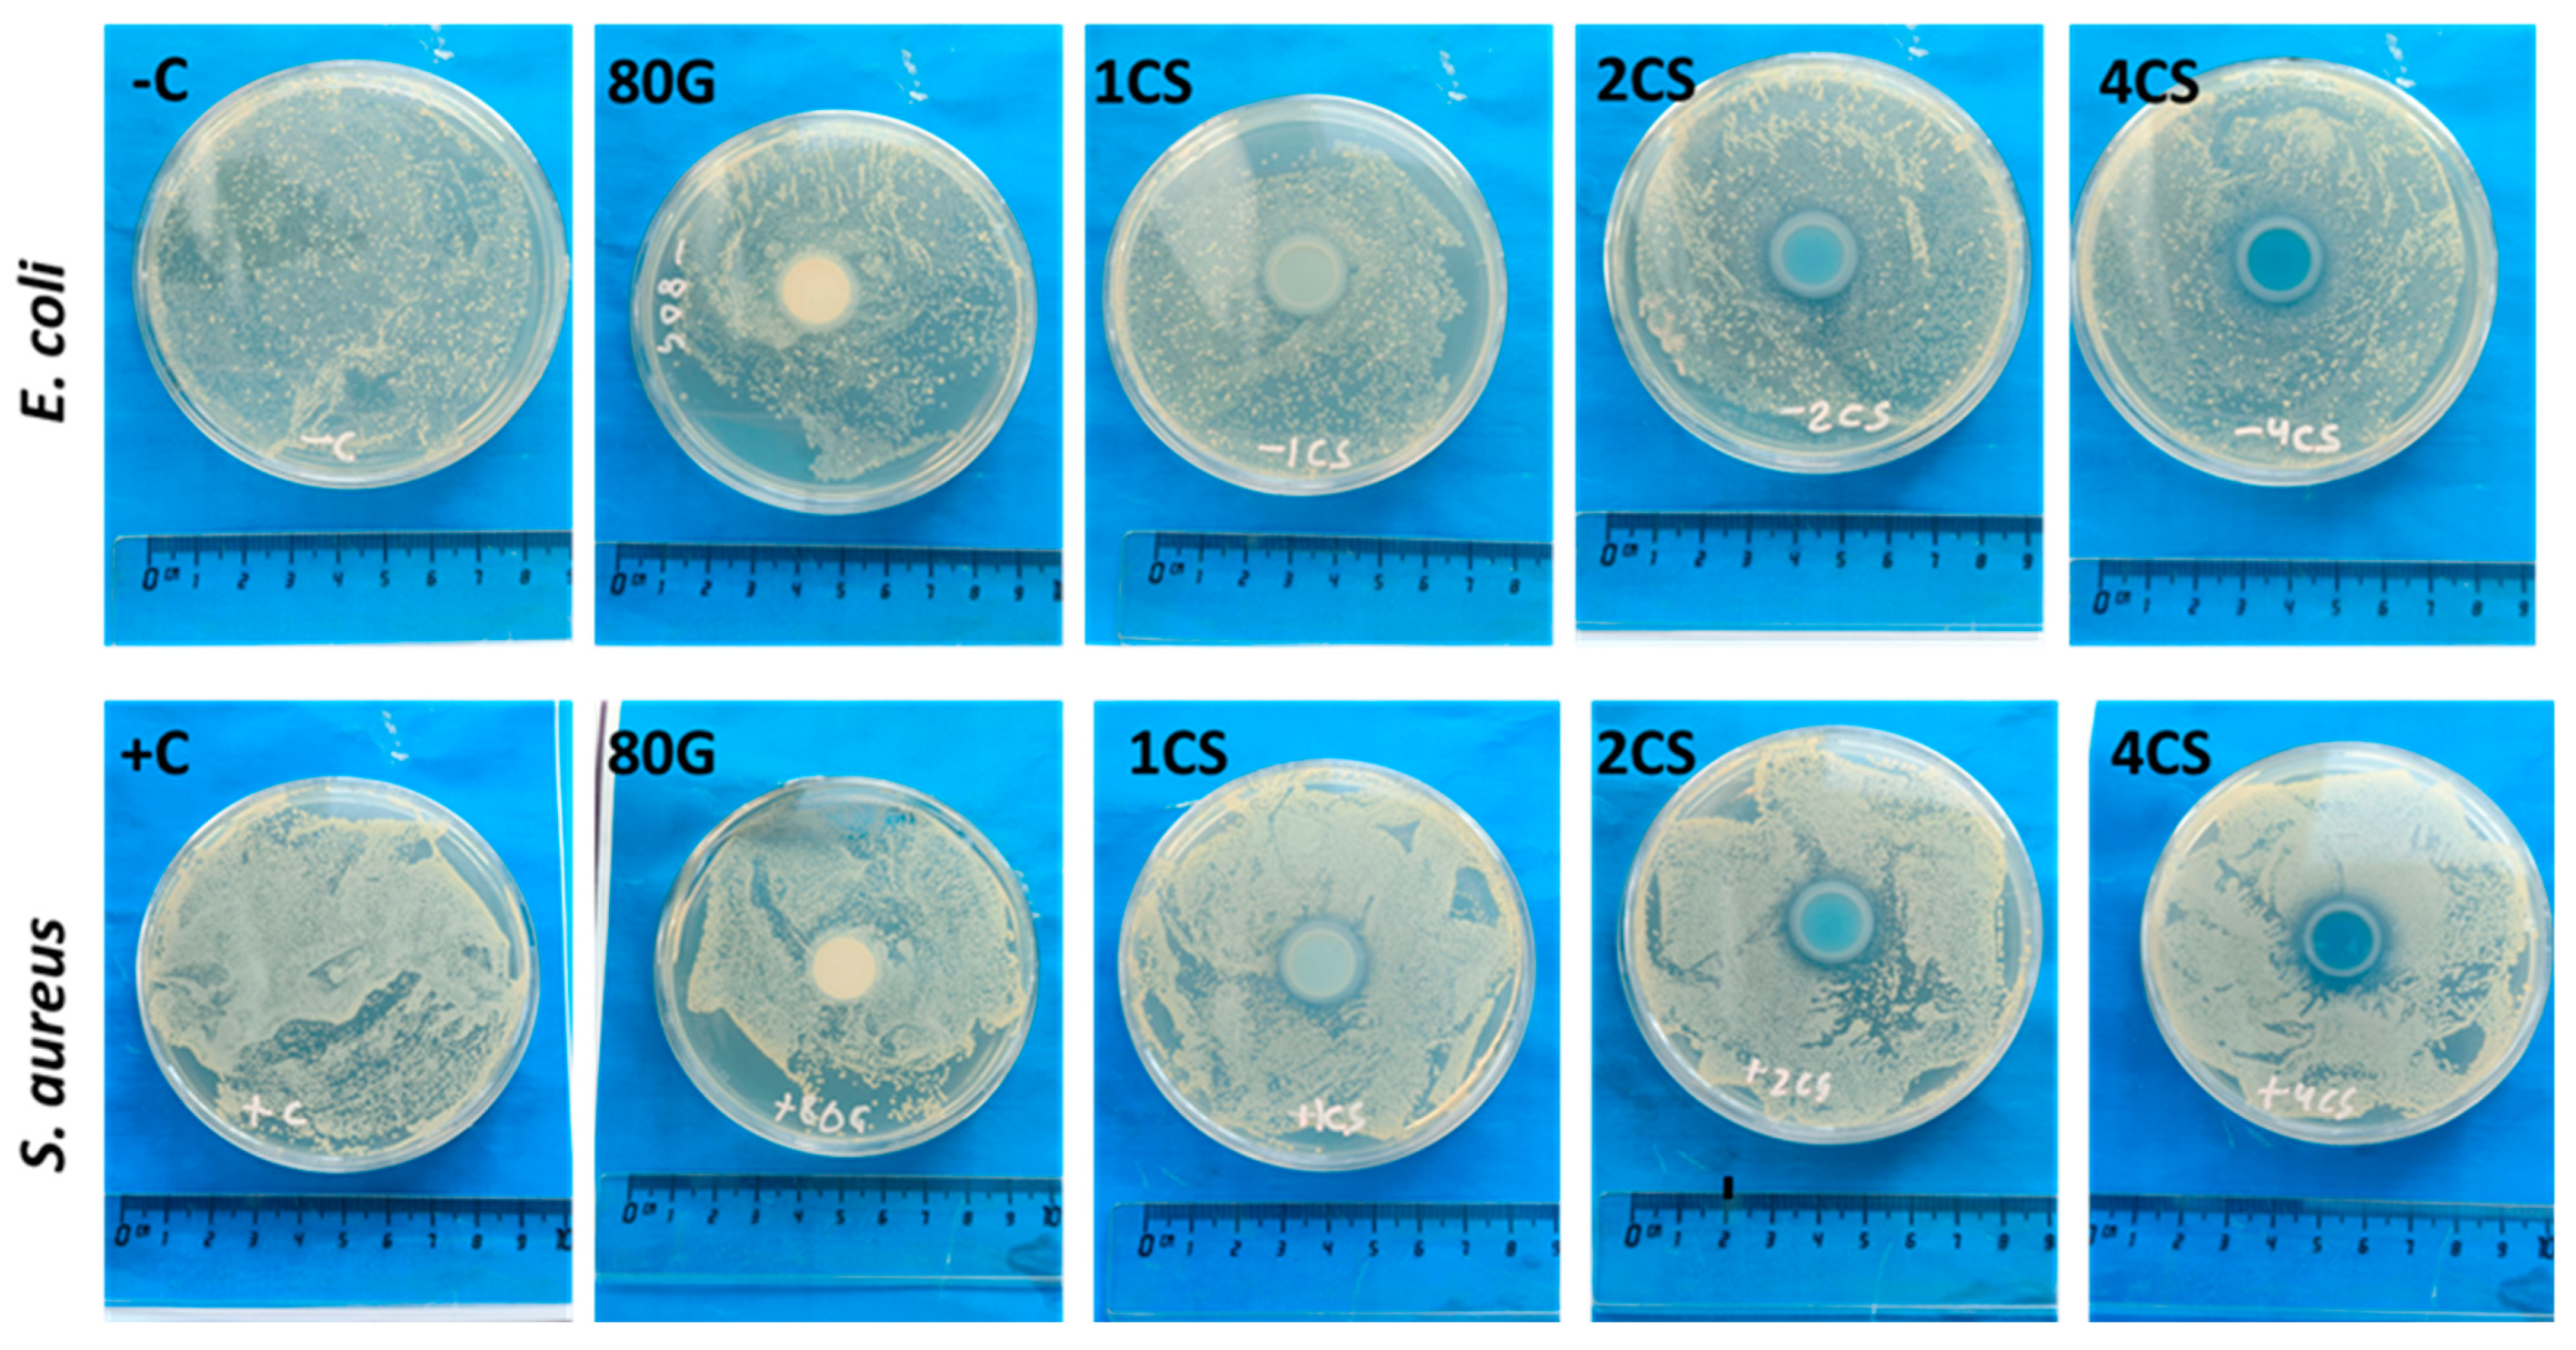
Gels 08 00743 g011 Gels 08 00743 g011

Influence of Copper-Strontium Co-Doping on Bioactivity, Cytotoxicity and Antibacterial Activity of Mesoporous Bioactive Glass
Abstract
1. Introduction
2. Results and Discussion
2.1. Physiochemical and Textural Characterisations of MBG
2.2. In Vitro Bioactivity Assessment
2.2.1. Ions Release Profile and pH Change
2.2.2. Bioactivity on MBG Surfaces
2.3. In Vitro Cytotoxicity Assessment
2.4. In Vitro Antibacterial Assessment
3. Conclusions
4. Materials and Methods
4.1. Materials
4.2. Preparation of Mesoporous Bioactive Glass
4.3. MBG Powder Characterization
4.4. In Vitro Bioactivity Assessment
4.5. In Vitro Cytotoxicity Assessment
4.6. Antibacterial Assessment
4.7. Statistical Analysis
Author Contributions
Funding
Institutional Review Board Statement
Informed Consent Statement
Data Availability Statement
Acknowledgments
Conflicts of Interest
References
- Vallet-Regi, M.; Salinas, A.J. Mesoporous bioactive glasses for regenerative medicine. Mater. Today Bio. 2021, 11, 100121. [Google Scholar] [CrossRef] [PubMed]
- Lalzawmliana, V.; Anand, A.; Roy, M.; Kundu, B.; Nandi, S.K. Mesoporous bioactive glasses for bone healing and biomolecules delivery. Mater. Sci. Eng. C 2020, 106, 110180. [Google Scholar] [CrossRef] [PubMed]
- Anand, A.; Lalzawmliana, V.; Kumar, V.; Das, P.; Devi, K.B.; Maji, A.K.; Kundu, B.; Roy, M.; Nandi, S.K. Preparation and in vivo biocompatibility studies of different mesoporous bioactive glasses. J. Mech. Behav. Biomed. Mater. 2019, 89, 89–98. [Google Scholar] [CrossRef]
- Anand, A.; Das, P.; Nandi, S.K.; Kundu, B. Development of antibiotic loaded mesoporous bioactive glass and its drug release kinetics. Ceram. Int. 2020, 46, 5477–5483. [Google Scholar] [CrossRef]
- Zhu, Y.; Wu, C.; Ramaswamy, Y.; Kockrick, E.; Simon, P.; Kaskel, S.; Zreiqat, H. Preparation, characterization and in vitro bioactivity of mesoporous bioactive glasses (MBGs) scaffolds for bone tissue engineering. Microporous Mesoporous Mater. 2008, 112, 494–503. [Google Scholar] [CrossRef]
- Carlisle, E.M. Silicon: A possible factor in bone calcification. Science 1970, 167, 279–280. [Google Scholar] [CrossRef] [PubMed]
- Beattie, J.H.; Avenell, A. Trace element nutrition and bone metabolism. Nutr. Res. Rev. 1992, 5, 167–188. [Google Scholar] [CrossRef]
- Hoppe, A.; Guldal, N.S.; Boccaccini, A.R. A review of the biological response to ionic dissolution products from bioactive glasses and glass-ceramics. Biomaterials 2011, 32, 2757–2774. [Google Scholar] [CrossRef]
- Borkow, G.; Gabbay, J. Copper as a biocidal tool. Curr. Med. Chem. 2005, 12, 2163–2175. [Google Scholar] [CrossRef]
- Arredondo, M.; Nunez, M.T. Iron and copper metabolism. Mol. Asp. Med. 2005, 26, 313–327. [Google Scholar] [CrossRef]
- Hu, G.f. Copper stimulates proliferation of human endothelial cells under culture. J. Cell. Biochem. 1998, 69, 326–335. [Google Scholar] [CrossRef]
- Sen, C.K.; Khanna, S.; Venojarvi, M.; Trikha, P.; Ellison, E.C.; Hunt, T.K.; Roy, S. Copper-induced vascular endothelial growth factor expression and wound healing. Am. J. Physiol.-Heart Circ. Physiol. 2002, 282, H1821–H1827. [Google Scholar] [CrossRef] [PubMed]
- Stanic, V.; Dimitrijevic, S.; Antic-Stankovic, J.; Mitric, M.; Jokic, B.; Plećaš, I.B.; Raičević, S. Synthesis, characterization and antimicrobial activity of copper and zinc-doped hydroxyapatite nanopowders. Appl. Surf. Sci. 2010, 256, 6083–6089. [Google Scholar] [CrossRef]
- Sampath Kumar, T.S.; Madhumathi, K. Antibacterial potential of nanobioceramics used as drug carriers. In Handbook of Bioceramics and Biocomposites; Springer: Berlin, Germany, 2016; pp. 1333–1373. [Google Scholar]
- Wu, C.; Zhou, Y.; Xu, M.; Han, P.; Chen, L.; Chang, J.; Xiao, Y. Copper-containing mesoporous bioactive glass scaffolds with multifunctional properties of angiogenesis capacity, osteostimulation and antibacterial activity. Biomaterials 2013, 34, 422–433. [Google Scholar] [CrossRef]
- Ruparelia, J.P.; Chatterjee, A.K.; Duttagupta, S.P.; Mukherji, S. Strain specificity in antimicrobial activity of silver and copper nanoparticles. Acta Biomater. 2008, 4, 707–716. [Google Scholar] [CrossRef]
- Yoon, K.-Y.; Byeon, J.H.; Park, J.-H.; Hwang, J. Susceptibility constants of Escherichia coli and Bacillus subtilis to silver and copper nanoparticles. Sci. Total Environ. 2007, 373, 572–575. [Google Scholar] [CrossRef]
- Boivin, G.; Deloffre, P.; Perrat, B.; Panczer, G.; Boudeulle, M.; Mauras, Y.; Allain, P.; Tsouderos, Y.; Meunier, P.J. Strontium distribution and interactions with bone mineral in monkey iliac bone after strontium salt (S 12911) administration. J. Bone Miner. Res. 1996, 11, 1302–1311. [Google Scholar] [CrossRef]
- Habibovic, P.; Barralet, J.E. Bioinorganics and biomaterials: Bone repair. Acta Biomater. 2011, 7, 3013–3026. [Google Scholar] [CrossRef]
- Verberckmoes, S.C.; De Broe, M.E.; D’Haese, P.C. Dose-dependent effects of strontium on osteoblast function and mineralization. Kidney Int. 2003, 64, 534–543. [Google Scholar] [CrossRef]
- Qiu, K.; Zhao, X.J.; Wan, C.X.; Zhao, C.S.; Chen, Y.W. Effect of strontium ions on the growth of ROS17/2.8 cells on porous calcium polyphosphate scaffolds. Biomaterials 2006, 27, 1277–1286. [Google Scholar] [CrossRef]
- Wang, X.; Li, X.; Ito, A.; Sogo, Y. Synthesis and characterization of hierarchically macroporous and mesoporous CaO-MO-SiO2-P2O5 (M = Mg, Zn, Sr) bioactive glass scaffolds. Acta Biomater. 2011, 7, 3638–3644. [Google Scholar] [CrossRef] [PubMed]
- Wu, C.; Zhou, Y.; Lin, C.; Chang, J.; Xiao, Y. Strontium-containing mesoporous bioactive glass scaffolds with improved osteogenic/cementogenic differentiation of periodontal ligament cells for periodontal tissue engineering. Acta Biomater. 2012, 8, 3805–3815. [Google Scholar] [CrossRef] [PubMed]
- Bari, A.; Molino, G.; Fiorilli, S.; Vitale-Brovarone, C. Novel multifunctional strontium-copper co-substituted mesoporous bioactive particles. Mater. Lett. 2018, 223, 37–40. [Google Scholar] [CrossRef]
- Balasubramanian, P.; Salinas, A.J.; Sanchez-Salcedo, S.; Detsch, R.; Vallet-Regi, M.; Boccaccini, A.R. Induction of VEGF secretion from bone marrow stromal cell line (ST-2) by the dissolution products of mesoporous silica glass particles containing CuO and SrO. J. Non-Cryst. Solids 2017, 500, 217–224. [Google Scholar] [CrossRef]
- Arcos, D.; Vallet-Regi, M. Sol-gel silica-based biomaterials and bone tissue regeneration. Acta Biomater. 2010, 6, 2874–2888. [Google Scholar] [CrossRef] [PubMed]
- Fiume, E.; Migneco, C.; Verne, E.; Baino, F. Comparison between bioactive sol-gel and melt-derived glasses/glass-ceramics based on the multicomponent SiO2-P2O5-CaO-MgO-Na2O-K2O system. Materials 2020, 13, 540. [Google Scholar] [CrossRef] [PubMed]
- Hesaraki, S.; Gholami, M.; Vazehrad, S.; Shahrabi, S. The effect of Sr concentration on bioactivity and biocompatibility of sol-gel derived glasses based on CaO-SrO-SiO2-P2O5 quaternary system. Mater. Sci. Eng. C 2010, 30, 383–390. [Google Scholar] [CrossRef]
- Chen, J.; Zeng, L.; Chen, X.; Liao, T.; Zheng, J. Preparation and characterization of bioactive glass tablets and evaluation of bioactivity and cytotoxicity in vitro. Bioact. Mater. 2018, 3, 315–321. [Google Scholar] [CrossRef]
- Lopez-Noriega, A.; Arcos, D.; Izquierdo-Barba, I.; Sakamoto, Y.; Terasaki, O.; Vallet-Regi, M. Ordered mesoporous bioactive glasses for bone tissue regeneration. Chem. Mater. 2006, 18, 3137–3144. [Google Scholar] [CrossRef]
- Thommes, M. Physical adsorption characterization of nanoporous materials. Chem. Ing. Tech. 2010, 82, 1059–1073. [Google Scholar] [CrossRef]
- Jimenez-Holguin, J.; Sánchez-Salcedo, S.; Vallet-RegÃ, M.; Salinas, A.J. Development and evaluation of copper-containing mesoporous bioactive glasses for bone defects therapy. Microporous Mesoporous Mater. 2020, 308, 110454. [Google Scholar] [CrossRef] [PubMed]
- Sanchez, C.; Boissiere, C.; Grosso, D.; Laberty, C.; Nicole, L. Design, synthesis, and properties of inorganic and hybrid thin films having periodically organized nanoporosity. Chem. Mater. 2008, 20, 682–737. [Google Scholar] [CrossRef]
- Kimura, T. Evaporation-induced self-assembly process controlled for obtaining highly ordered mesoporous materials with demanded morphologies. Chem. Rec. 2016, 16, 445–457. [Google Scholar] [CrossRef]
- Arcos, D.; Greenspan, D.C.; Vallet-Regi, M. Influence of the stabilization temperature on textural and structural features and ion release in SiO2-CaO-P2O5 Sol-Gel glasses. Chem. Mater. 2002, 14, 1515–1522. [Google Scholar] [CrossRef]
- Jones, J.R. Reprint of: Review of bioactive glass: From Hench to hybrids. Acta Biomater. 2015, 23, S53–S82. [Google Scholar]
- Gough, J.E.; Jones, J.R.; Hench, L.L. Nodule formation and mineralisation of human primary osteoblasts cultured on a porous bioactive glass scaffold. Biomaterials 2004, 25, 2039–2046. [Google Scholar] [CrossRef]
- Galow, A.-M.; Rebl, A.; Koczan, D.; Bonk, S.M.; Baumann, W.; Gimsa, J. Increased osteoblast viability at alkaline pH in vitro provides a new perspective on bone regeneration. Biochem. Biophys. Rep. 2017, 10, 17–25. [Google Scholar] [CrossRef]
- Bui, X.V.; Dang, T.H. Bioactive glass 58S prepared using an innovation sol-gel process. Process. Appl. Ceram. 2019, 13, 98–103. [Google Scholar] [CrossRef]
- Fu, Q.; Rahaman, M.N.; Fu, H.; Liu, X. Silicate, borosilicate, and borate bioactive glass scaffolds with controllable degradation rate for bone tissue engineering applications. I. Preparation and in vitro degradation. J. Biomed. Mater. Res. Part A 2010, 95, 164–171. [Google Scholar] [CrossRef]
- Heras, C.; Sanchez-Salcedo, S.; Lozano, D.; Peña, J.; Esbrit, P.; Vallet-Regi, M.; Salinas, A.J. Osteostatin potentiates the bioactivity of mesoporous glass scaffolds containing Zn2+ ions in human mesenchymal stem cells. Acta Biomater. 2019, 89, 359–371. [Google Scholar] [CrossRef]
- ISO/EN 10993-5; Biological Evaluation of Medical Devices. Part 5. Test for Cytotoxicity: In Vitro Methods. 8.2. Tests on Extracts. International Organization for Standardization: Geneva, Switzerland, 1992.
- Nescakova, Z.; Zheng, K.; Liverani, L.; Nawaz, Q.; Galusková, D.; Kaňková, H.; Michálek, M.; Galusek, D.; Boccaccini, A.R. Multifunctional zinc ion doped sol-gel derived mesoporous bioactive glass nanoparticles for biomedical applications. Bioact. Mater. 2019, 4, 312–321. [Google Scholar] [CrossRef] [PubMed]
- Balasubramanian, P.; Hupa, L.; Jokic, B.; Detsch, R.; Grünewald, A.; Boccaccini, A.R. Angiogenic potential of boron-containing bioactive glasses: In vitro study. J. Mater. Sci. 2017, 52, 8785–8792. [Google Scholar] [CrossRef]
- Kurtuldu, F.; Mutlu, N.; Michálek, M.; Zheng, K.; Masar, M.; Liverani, L.; Chen, S.; Galusek, D.a.; Boccaccini, A.R. Cerium and gallium containing mesoporous bioactive glass nanoparticles for bone regeneration: Bioactivity, biocompatibility and antibacterial activity. Mater. Sci. Eng. C 2021, 124, 112050. [Google Scholar] [CrossRef] [PubMed]
- Modglin, V.C.; Brown, R.F.; Jung, S.B.; Day, D.E. Cytotoxicity assessment of modified bioactive glasses with MLO-A5 osteogenic cells in vitro. J. Mater. Sci. Mater. Med. 2013, 24, 1191–1199. [Google Scholar] [CrossRef] [PubMed]
- Effah Kaufmann, E.A.B.; Ducheyne, P.; Shapiro, I.M. Evaluation of osteoblast response to porous bioactive glass (45S5) substrates by RT-PCR analysis. Tissue Eng. 2000, 6, 19–28. [Google Scholar] [CrossRef]
- Bosetti, M.; Cannas, M. The effect of bioactive glasses on bone marrow stromal cells differentiation. Biomaterials 2005, 26, 3873–3879. [Google Scholar] [CrossRef]
- Parra, A.; Toro, M.; Jacob, R.; Navarrete, P.; Troncoso, M.; Figueroa, G.; Reyes-Jara, A.l. Antimicrobial effect of copper surfaces on bacteria isolated from poultry meat. Braz. J. Microbiol. 2018, 49, 113–118. [Google Scholar] [CrossRef]
- Oyane, A.; Kim, H.M.; Furuya, T.; Kokubo, T.; Miyazaki, T.; Nakamura, T. Preparation and assessment of revised simulated body fluids. J. Biomed. Mater. Res. Part A Off. J. Soc. Biomater. Jpn. Soc. Biomater. Aust. Soc. Biomater. Korean Soc. Biomater. 2003, 65, 188–195. [Google Scholar] [CrossRef]

| Actual Compositions | |||||
|---|---|---|---|---|---|
| Sample | SiO2 (mol.%) | CaO (mol.%) | P2O5 (mol.%) | SrO (mol.%) | CuO (mol.%) |
| 80G | 84.9 ± 0.4 | 14.8 ± 0.4 | 0.28 ± 0.01 | - | - |
| 1CS | 86.4 ± 0.2 | 12.2 ± 02 | 0.41 ± 0.03 | 0.51 ± 0.01 | 0.5 ± 0.01 |
| 2CS | 83.8 ± 0.1 | 13.4 ± 0.3 | 0.31 ± 0.02 | 1.1 ± 0.02 | 1.2 ± 0.01 |
| 4CS | 81.8 ± 0.1 | 12.6 ± 0.05 | 0.8 ± 0.06 | 2.2 ± 0.01 | 2.4 ± 0.01 |
| Sample | SBET (m2/g) | VP (cm3/g) | DP (nm) |
|---|---|---|---|
| 80G | 253 | 0.33 | 5.20 |
| 1CS | 348 | 0.44 | 5.06 |
| 2CS | 378 | 0.45 | 4.80 |
| 4CS | 332 | 0.39 | 4.71 |
| Sample | Zone of Inhibition (mm) | |
|---|---|---|
| E. coli | S. aureus | |
| 80G | - | - |
| 1CS | ~1.5 | ~2 |
| 2CS | ~2.3 | ~2.5 |
| 4CS | ~3.5 | ~3.5 |
| Acronym | CaO | CuO | SrO | SiO2 | P2O5 |
|---|---|---|---|---|---|
| 80G | 15 | 0 | 0 | 80 | 5 |
| 1CS | 14 | 0.5 | 0.5 | 80 | 5 |
| 2CS | 13 | 1 | 1 | 80 | 5 |
| 4CS | 11 | 2 | 2 | 80 | 5 |
Publisher’s Note: MDPI stays neutral with regard to jurisdictional claims in published maps and institutional affiliations. |
© 2022 by the authors. Licensee MDPI, Basel, Switzerland. This article is an open access article distributed under the terms and conditions of the Creative Commons Attribution (CC BY) license (https://creativecommons.org/licenses/by/4.0/).
Share and Cite
Anand, A.; Sengupta, S.; Kaňková, H.; Švančárková, A.; Beltrán, A.M.; Galusek, D.; Boccaccini, A.R.; Galusková, D. Influence of Copper-Strontium Co-Doping on Bioactivity, Cytotoxicity and Antibacterial Activity of Mesoporous Bioactive Glass. Gels 2022, 8, 743. https://doi.org/10.3390/gels8110743
Anand A, Sengupta S, Kaňková H, Švančárková A, Beltrán AM, Galusek D, Boccaccini AR, Galusková D. Influence of Copper-Strontium Co-Doping on Bioactivity, Cytotoxicity and Antibacterial Activity of Mesoporous Bioactive Glass. Gels. 2022; 8(11):743. https://doi.org/10.3390/gels8110743
Chicago/Turabian StyleAnand, Akrity, Susanta Sengupta, Hana Kaňková, Anna Švančárková, Ana M. Beltrán, Dušan Galusek, Aldo R. Boccaccini, and Dagmar Galusková. 2022. "Influence of Copper-Strontium Co-Doping on Bioactivity, Cytotoxicity and Antibacterial Activity of Mesoporous Bioactive Glass" Gels 8, no. 11: 743. https://doi.org/10.3390/gels8110743
APA StyleAnand, A., Sengupta, S., Kaňková, H., Švančárková, A., Beltrán, A. M., Galusek, D., Boccaccini, A. R., & Galusková, D. (2022). Influence of Copper-Strontium Co-Doping on Bioactivity, Cytotoxicity and Antibacterial Activity of Mesoporous Bioactive Glass. Gels, 8(11), 743. https://doi.org/10.3390/gels8110743

